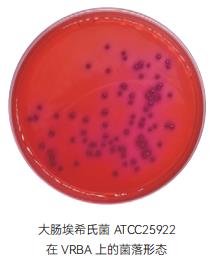
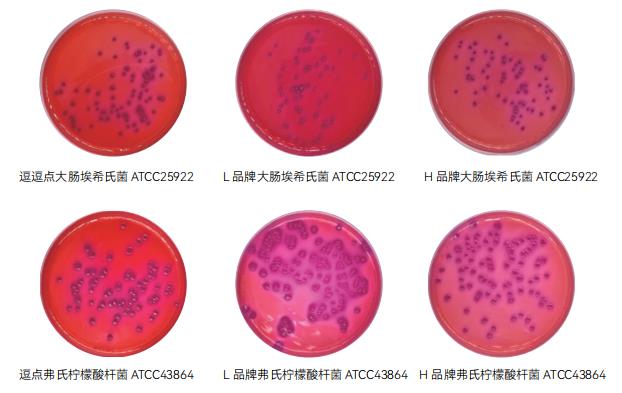

证实试验:从接种同一样品浓度的 VRBA 平板上共挑取 10 个不同类型的典型和可疑菌落,分别移种于 BGLB 肉汤管内,36℃±1℃培养 24 h ~ 48 h,观察产气情况。凡 BGLB 肉汤管产气,即可报告为大肠菌群阳性。

4. 大肠菌群平板计数的报告
•经最后证实为大肠菌群阳性的试管比例乘以计数的平板菌落数 , 再乘以稀释倍数 , 即为每 g(mL) 样品中大肠菌群数。例 :10-4 样品稀释液 1mL, 在 VRBA 平板上有 100 个典型和可疑菌落 , 挑取其中 10 个接种 BGLB 肉汤管 , 证实有 6 个阳性管 , 则该样品的大肠菌群数为 :100×6/10×104 /g(mL)=6.0×105 CFU/g(mL)。若所有稀释度 ( 包括液体样品原液 ) 平板均无菌落生长 , 则以小于 1 乘以最低稀释倍数计算。
•若所有稀释度(包括液体样品原液)平板均无菌落生长,则以小于 1 乘以最低稀释倍数计算。
四、质量控制
1. 实验过程中,每批样品稀释液都要做空白对照。
2. 为了控制环境污染,每次检验过程中,于检验台上打开两块计数琼脂平板,并在检验环境中暴露不少于 15 分钟,将此平板与本批次样品同时进行培养,以掌握检验过程中是否存在来自检验环境的污染。
3. 定期使用大肠埃希氏菌 ATCC25922 或相应定量活菌参考品,在 P2 实验室或阳性对照实验室内,用适当的食品样品进行阳性实验验证,并进行记录,此次验证实验至少每 2 个月进行 1 次。
月桂基硫酸盐胰蛋白胨肉汤(LST)
1、产品用途:月桂基硫酸盐胰蛋白胨肉汤用于多管发酵法测定大肠菌群和粪大肠菌群。
2、检验原理:胰蛋白胨提供碳源和氮源满足细菌生长的需求 ; 氯化钠可维持均衡的渗透压 ; 乳糖是大肠菌群可发酵的糖类 ; 磷酸二氢钾和磷酸氢二钾是缓冲剂;月桂基硫酸钠可抑制非大肠菌群细菌的生长。
3、月桂基硫酸盐胰蛋白胨肉汤(LST) 验证数据

| 样品名称 |
质控菌株 |
厂家 |
参比培养基计数(TSA) |
生长率(或特征) |
评定标准 |
结果判定 |
月桂基
硫酸盐
胰蛋白
胨肉汤
(LST) |
大肠埃
希氏菌
ATCC25922 |
逗点 |
26 |
液体混浊且产气 |
混浊度 2 ,
且气体充满管内 1/3 |
符合 |
| L 品牌 |
| 符合 |
| H 品牌 |
符合 |
| 金黄色 葡萄球菌 ATCC6538 |
逗点 |
41 |
符合 |
| L 品牌 |
符合 |
| H 品牌 |
符合 |
枯草芽
孢杆菌 ATCC6633 |
逗点 |
2118 |
未生长 |
混浊度 0(不生长) |
符合 |
| L 品牌 |
符合 |
| H 品牌 |
符合 |
4、典型特征图片:


5、验证结果小结:
1、生长率:目标菌大肠埃希氏菌 ATCC25922 、弗氏柠檬酸杆菌 ATCC43864、逗点、L 品牌、H 品牌的混浊度、产气均满足要求;
2、选择性:粪肠球菌 ATCC29212,逗点、L 品牌、H 品牌均满足不生长、不产气的要求;
3、感观:逗点、L 品牌、H 品牌外观颜色无明显差异。
煌绿乳糖胆盐肉汤(BGLB)
1、产品用途:用于多管发酵法测定大肠菌群的确证试验。
2、检验原理:蛋白胨提供碳氮源;乳糖是可发酵的糖类;牛胆粉和煌绿抑制非肠杆菌科细菌。
3、煌绿乳糖胆盐肉汤(BGLB) 验证数据
| 样品名称 |
质控菌株 |
厂家 |
参比培养基计数(TSA) |
生长率(或特征) |
评定标准 |
结果判定 |
煌绿乳
糖胆盐
肉汤
(BGLB) |
大肠埃
希氏菌
ATCC25922 |
逗点 |
26 |
液体混浊且产气 |
混浊度 2 ,
且气体充满管内 1/3 |
符合 |
| L 品牌 |
| 符合 |
| K 品牌 |
符合 |
弗氏柠檬
酸杆菌
ATCC43864 |
逗点 |
41 |
符合 |
| L 品牌 |
符合 |
| K 品牌 |
符合 |
| 粪肠球菌 ATCC29212 |
逗点 |
2118 |
未生长 |
混浊度 0(不生长)
或混浊度 1(微弱生长),
不产气 |
符合 |
| L 品牌 |
符合 |
| K 品牌 |
符合 |
4、典型特征图片:


5、验证结果小结:
1、生长率:目标菌大肠埃希氏菌 ATCC25922 、弗氏柠檬酸杆菌 ATCC43864、逗点、L 品牌、K 品牌的混浊度、产气均满足要求;
2、选择性:粪肠球菌 ATCC29212,逗点、L 品牌、K 品牌均满足不生长、不产气的要求;
3、感观:逗点、L 品牌煌绿乳糖胆盐肉汤颜色为蓝绿色,K 品牌煌绿乳糖胆盐肉汤颜色为青绿色。
结晶紫中性红胆盐琼脂(VRBA)
1. 产品用途:用于水或食品中大肠菌群平板菌落计数。
2. 检验原理:蛋白胨和酵母膏粉提供碳氮源和微量元素;乳糖是可发酵的糖类;氯化钠可维持均衡的渗透压;3 号胆盐和结晶紫抑制革兰氏阳性菌,特别抑制革兰氏阳性杆菌和粪链球菌;中性红为 pH 指示剂。
| 样品名称 |
质控菌株 |
厂家 |
待测培养基计数 |
参比培养基计数(TSA) |
生长率(或特征) |
评定标准 |
结果判定 |
结晶紫
中性红 胆盐琼脂 (VRBA) |
大肠埃
希氏菌
ATCC25922 |
逗点 |
79 |
60 |
PR=1.3 |
PR≥0.7 |
符合 |
| L 品牌 |
| 72 |
PR=1.2 |
符合 |
| H 品牌 |
71 |
PR=1.2 |
符合 |
弗氏柠檬
酸杆菌
ATCC43864 |
逗点 |
76 |
115 |
PR=0.7 |
PR≥0.7 |
符合 |
| L 品牌 |
113 |
PR=1.0 |
符合 |
| H 品牌 |
85 |
PR=0.7 |
符合 |
| 粪肠球菌 ATCC29212 |
逗点 |
/ |
/
/
/ |
G=0 |
G<5 |
符合 |
| L 品牌 |
/ |
G=0 |
符合 |
| H 品牌 |
/ |
G=0 |
符合 |
1. 大肠埃希氏菌 ATCC25922 在 VRBA 板上的菌落特征:有或无沉淀环的紫红色或红色菌落;
2. 弗氏柠檬酸杆菌 ATCC43864 在 VRBA 板上的菌落特征:有或无沉淀环的紫红色或红色菌落 ; 3. 粪肠球菌 ATCC 29212 在 VRBA 板上的菌落特征:选择性 G<5; |


验证结果小结
1. 生长率:目标菌大肠埃希氏菌 ATCC25922、弗氏柠檬酸杆菌 ATCC43864,逗点、L 品牌、H 品牌均满足国标PR≥0.7 的要求,逗点、H 品牌、L 品牌都有明显胆酸盐沉淀。
2. 选择性:粪肠球菌 ATCC 29212 ,逗点、L 品牌、H 品牌均满足国标 G≤1 的要求。
3. 感观:H 品牌平板颜色为紫红色偏粉,L 品牌平板颜色为紫红色偏紫,逗点颜色为紫红偏红色。其中逗点颜色最深,H 品牌颜色最浅,L 品牌在两者之间。